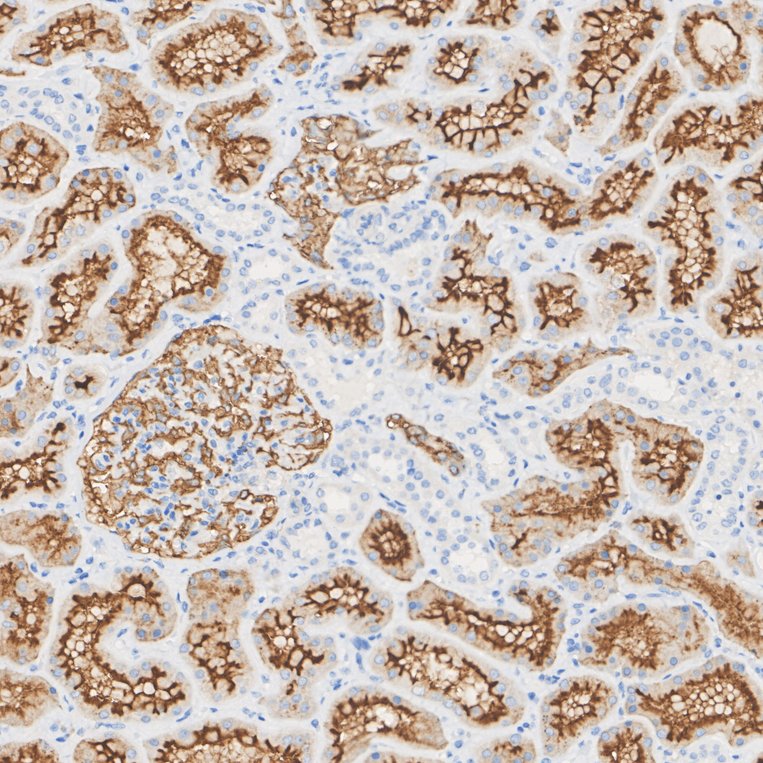
EM1901-25_6.jpg

CD10 Mouse Monoclonal Antibody [A1G4]

cat.: EM1901-25
| Product Type: | Mouse monoclonal IgG1, primary antibodies |
|---|---|
| Species reactivity: | Human |
| Applications: | WB, IHC-P, FC |
| Clonality: | Monoclonal |
| Clone number: | A1G4 |
| Form: | Liquid |
| Storage condition: | Shipped at 4℃. Store at +4℃ short term (1-2 weeks). It is recommended to aliquot into single-use upon delivery. Store at -20℃ long term. |
| Storage buffer: | 1*PBS (pH7.4), 0.2% BSA, 50% Glycerol. Preservative: 0.05% Sodium Azide. |
| Concentration: | 2ug/ul |
| Purification: | Protein G affinity purified. |
| Molecular weight: | Predicted band size: 86 kDa |
| Isotype: | IgG1 |
| Immunogen: | Synthetic peptide within human CD10 aa 200-300. |
| Positive control: | Daudi cell lysate, human prostate tissue, human kidney tissue, human small intestine tissue, 293 cell. |
| Subcellular location: | Cell membrane. |
| Recommended Dilutions:
WB IHC-P FC |
1:500-1:2,000 1:200-1:1,000 1:50-1:100 |
| Uniprot #: | SwissProt: P08473 Human |
| Alternative names: | Atriopeptidase CALLA CD10 CD10 antigen Common acute lymphocytic leukemia antigen DKFZp686O16152 EC 3.4.24.11 Enkephalinase EPN Membrane metallo endopeptidase (neutral endopeptidase, enkephalinase) Membrane metallo endopeptidase (neutral endopeptidase, enkephalinase, CALLA, CD10) Membrane metallo endopeptidase Membrane metallo endopeptidase variant 1 Membrane metallo endopeptidase variant 2 Membrane metalloendopeptidase Membrane metalloendopeptidase neutral endopeptidase enkephalinase Membrane metalloendopeptidase neutral endopeptidase enkephalinase CALLA CD10 Membrane metalloendopeptidase variant 1 Membrane metalloendopeptidase variant 2 MGC126681 MGC126707 MME NEP NEP_HUMAN Neprilysin neprilysin-390 neprilysin-411 Neutral endopeptidase 24.11 Neutral endopeptidase Neutral endopeptidase, membrane-associated SFE Skin fibroblast elastase |
Images

|
Fig1: Western blot analysis of CD10 on Daudi cell lysate. Proteins were transferred to a PVDF membrane and blocked with 5% BSA in PBS for 1 hour at room temperature. The primary antibody (EM1901-25, 1/500) was used in 5% BSA at room temperature for 2 hours. Goat Anti-Mouse IgG - HRP Secondary Antibody (HA1006) at 1:5,000 dilution was used for 1 hour at room temperature. |

|
Fig2: Immunohistochemical analysis of paraffin-embedded human prostate tissue using anti-CD10 antibody. The section was pre-treated using heat mediated antigen retrieval with Tris-EDTA buffer (pH 8.0-8.4) for 20 minutes.The tissues were blocked in 5% BSA for 30 minutes at room temperature, washed with ddH2O and PBS, and then probed with the primary antibody (EM1901-25, 1/800) for 30 minutes at room temperature. The detection was performed using an HRP conjugated compact polymer system. DAB was used as the chromogen. Tissues were counterstained with hematoxylin and mounted with DPX. |

|
Fig3:
Immunohistochemical analysis of paraffin-embedded human kidney tissue with Rabbit anti-CD10 antibody (EM1901-25) at 1/800 dilution. The section was pre-treated using heat mediated antigen retrieval with Tris-EDTA buffer (pH 9.0) for 20 minutes. The tissues were blocked in 1% BSA for 20 minutes at room temperature, washed with ddH2O and PBS, and then probed with the primary antibody (EM1901-25) at 1/800 dilution for 1 hour at room temperature. The detection was performed using an HRP conjugated compact polymer system. DAB was used as the chromogen. Tissues were counterstained with hematoxylin and mounted with DPX. |

|
Fig4: Immunohistochemical analysis of paraffin-embedded human small intestine tissue using anti-CD10 antibody. The section was pre-treated using heat mediated antigen retrieval with Tris-EDTA buffer (pH 8.0-8.4) for 20 minutes.The tissues were blocked in 5% BSA for 30 minutes at room temperature, washed with ddH2O and PBS, and then probed with the primary antibody (EM1901-25, 1/200) for 30 minutes at room temperature. The detection was performed using an HRP conjugated compact polymer system. DAB was used as the chromogen. Tissues were counterstained with hematoxylin and mounted with DPX. |

|
Fig5: Flow cytometric analysis of CD10 was done on 293 cells. The cells were fixed, permeabilized and stained with the primary antibody (EM1901-25, 1/100) (red). After incubation of the primary antibody at room temperature for an hour, the cells were stained with a Alexa Fluor 488-conjugated goat anti-Mouse IgG Secondary antibody at 1/500 dilution for 30 minutes.Unlabelled sample was used as a control (cells without incubation with primary antibody; black). |
|
Fig6:
Immunohistochemical analysis of paraffin-embedded human kidney tissue with Rabbit anti-CD10 antibody (EM1901-25) at 1/800 dilution. Heat mediated antigen retrieval with Tris-EDTA buffer (pH 9.0, epitope retrieval solution 2) for 20 mins. The section was incubated with EM1901-25 for 30 mins at room temperature. The immunostaining was performed on a Dartmon AS330 PLUS instrument. DAB was used as the chromogen. Tissues were counterstained with hematoxylin and mounted with DPX. |
Note: All products are “FOR RESEARCH USE ONLY AND ARE NOT INTENDED FOR DIAGNOSTIC OR THERAPEUTIC USE”.